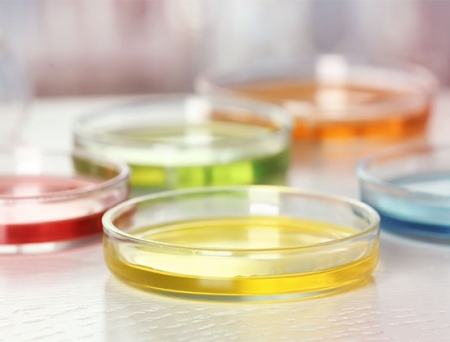
Glenmark Gets ANDA Approval for Esomeprazole Magnesium Delayed-Release Capsules

Glenmark has secured final approval by the United States Food & Drug Administration (US FDA) for Esomeprazole Magnesium Delayed-Release Capsules USP, 20 mg (OTC), determined by the FDA to be bioequivalent1 to Nexium 24 HR Delayed-Release Capsules, 20 mg (OTC), of Haleon U.S. Holdings LLC.
Esomeprazole Magnesium Delayed-Release Capsules USP, 20 mg (OTC), will be distributed in the US by Glenmark Therapeutics Inc., USA.
According to Nielsen syndicated data for the latest 52-week period ending May 18, 2024, the Nexium 24 HR Delayed-Release Capsules, 20 mg (OTC) market3 achieved annual sales of approximately USD 259.2 million.
Glenmark’s current portfolio consists of 197 products authorized for distribution in the U.S. marketplace and 50 ANDA’s pending approval with the U.S. FDA. In addition to these internal filings, Glenmark continues to identify and explore external development partnerships to supplement and accelerate the growth of its existing pipeline and portfolio.
Glenmark Pharmaceuticals Ltd. is a research-led, global pharmaceutical company, having a presence across Branded, Generics, and OTC segments; with a focus on therapeutic areas of respiratory, dermatology and oncology. The company has 11 world-class manufacturing facilities spread across 4 continents, and operations in over 80 countries.
In Vivo/Scrip 100 positions Glenmark amongst the Top 100 Companies Ranked by R&D and Pharmaceutical Sales, 2022; while Generics Bulletin/In Vivo places it in the Top 50 Generics and Biosimilars Companies Ranked by Sales, 2022. Glenmark’s Green House Gas (GHG) emission reduction targets have been approved in 2023 by the Science Based Target Initiative (SBTi), making it only the second pharmaceutical company in India to achieve this.